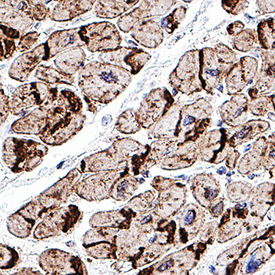

Human/Mouse/Rat N-Cadherin Antibody
R&D Systems, part of Bio-Techne | Catalog # AF6426


Key Product Details
Validated by
Species Reactivity
Validated:
Cited:
Applications
Validated:
Cited:
Label
Antibody Source
Product Specifications
Immunogen
Asp160-Ala724
Accession # P19022
Specificity
Clonality
Host
Isotype
Scientific Data Images for Human/Mouse/Rat N-Cadherin Antibody
Detection of Human, Mouse, and Rat N‑Cadherin by Western Blot.
Western blot shows lysates of A549 human lung carcinoma cell line, HeLa human cervical epithelial carcinoma cell line, C2C12 mouse myoblast cell line, and rat brain tissue. PVDF Membrane was probed with 0.5 µg/mL of Sheep Anti-Human/Mouse/Rat N-Cadherin Antigen Affinity-purified Polyclonal Antibody (Catalog # AF6426) followed by HRP-conjugated Anti-Sheep IgG Secondary Antibody (Catalog # HAF016). A specific band was detected for N-Cadherin at approximately 130 kDa (as indicated). This experiment was conducted under reducing conditions and using Immunoblot Buffer Group 1.N‑Cadherin in A549 Human Cell Line.
N-Cadherin was detected in immersion fixed A549 human lung carcinoma cell line using Sheep Anti-Human/Mouse/Rat N-Cadherin Affinity-purified Polyclonal Antibody (Catalog # AF6426) at 10 µg/mL for 3 hours at room temperature. Cells were stained using the NorthernLights™ 557-conjugated Anti-Sheep IgG Secondary Antibody (red; Catalog # NL010) and counterstained with DAPI (blue). Specific staining was localized to cell surfaces. View our protocol for Fluorescent ICC Staining of Cells on Coverslips.N‑Cadherin in Human Heart
N-Cadherin was detected in immersion fixed paraffin-embedded sections of human heart using Sheep Anti-Human/Mouse/Rat N-Cadherin Antigen Affinity-purified Polyclonal Antibody (Catalog # AF6426) at 1 µg/mL overnight at 4 °C. Tissue was stained using the Sheep IgG VisUCyte HRP Polymer Antibody (Catalog # VC006). Before incubation with the primary antibody, tissue was subjected to heat-induced epitope retrieval using Antigen Retrieval Reagent-Basic (Catalog # CTS013). Tissue was stained using DAB (brown) and counterstained with hematoxylin (blue). Specific staining was localized to intercalated disks between the myocardial cells. Staining was performed using our protocol for IHC Staining with VisUCyte HRP Polymer Detection Reagents.Applications for Human/Mouse/Rat N-Cadherin Antibody
CyTOF-ready
ELISA
This antibody functions as an ELISA detection antibody to detect human N-Cadherin when paired with Mouse Anti-Human N‑Cadherin Monoclonal Antibody (Catalog # MAB13883).
This product is intended for assay development on various assay platforms requiring antibody pairs. We recommend the Human N-Cadherin DuoSet ELISA Kit (Catalog # DY1388-05) for convenient development of a sandwich ELISA.
Flow Cytometry
Sample: A172 human glioblastoma cell line
Immunocytochemistry
Sample: Immersion fixed A549 human lung carcinoma cell line
Immunohistochemistry
Sample: Immersion-fixed paraffin-embedded sections of human heart
Western Blot
Sample: A549 human lung carcinoma cell line, HeLa human cervical epithelial carcinoma cell line, C2C12 mouse myoblast cell line, and rat brain tissue
Formulation, Preparation, and Storage
Purification
Reconstitution
Formulation
Shipping
Stability & Storage
- 12 months from date of receipt, -20 to -70 °C as supplied.
- 1 month, 2 to 8 °C under sterile conditions after reconstitution.
- 6 months, -20 to -70 °C under sterile conditions after reconstitution.
Background: N-Cadherin
N-Cadherin (Neural Cadherin; also CD325 and Cadherin-2) is a 130-135 kDa member of the "classical" (or type I) cadherin subfamily, cadherin superfamily of proteins. It is expressed on multiple cell types, including neurons, fibroblasts, Schwann cells, endothelial cells and hepatic stellate cells. N-Cadherin mediates homotypic binding, either in cis (same cell) or trans (adjacent cell). proN-Cadherin is expressed as an 881 amino acid (aa) type I transmembrane glycoprotein. It may be initially inserted into the ER, where the 15-20 kDa prodomain (aa 26-159) is cleaved by proprotein convertase, and the mature molecule (aa 160-906) is transported to the surface. Mature N-Cadherin contains a 565 aa extracellular region (aa 160-724) that possesses five cadherin domains (aa 160-714), and a 161 aa cytoplasmic tail that undergoes phosphorylation at Tyr785. There is one splice variant that contains a 10 aa substitution for aa 839-906. Over aa 160-724, human N Cadherin shares 98% aa identity with mouse N-Cadherin.
Long Name
Alternate Names
Gene Symbol
UniProt
Additional N-Cadherin Products
Product Documents for Human/Mouse/Rat N-Cadherin Antibody
Product Specific Notices for Human/Mouse/Rat N-Cadherin Antibody
For research use only